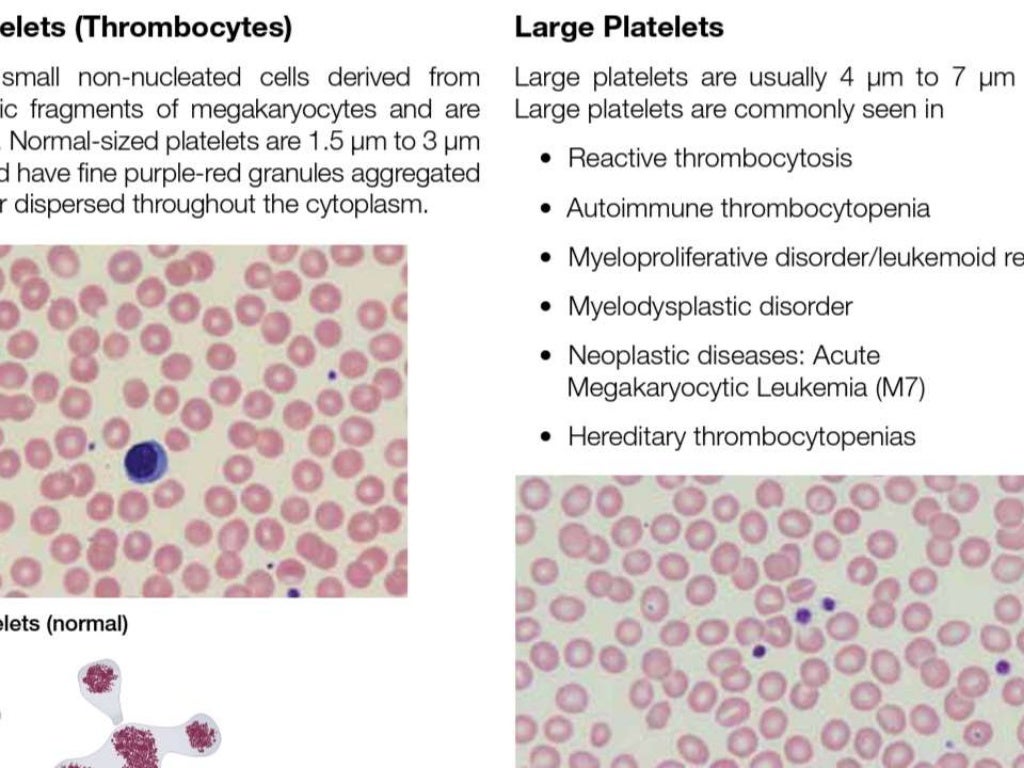

Blood Smear Interpretation Anemia Chart A low hemoglobin concentration and or low hematocrit are the parameters most widely used to diagnose anemia The reference range depends on age and sex of the patient as well as other factors such as altitude prevalence of
Direct blood smear or blood in EDTA can be used What are the indications for RBC Morphology Interpretations To diagnose anemia For typing of the anemia How will you Summarize RBC Morphology and Interpretations Anemia may be classified roughly based on Hb level Severe anemia when the Hb is
Blood Smear Interpretation Anemia Chart
Blood Smear Interpretation Anemia Chart
https://www.researchgate.net/publication/261547808/figure/fig2/AS:410728738639873@1474936770451/Peripheral-blood-smear-of-a-patient-with-microangiopathic-haemolytic-anemia-with.png
Anemia Lesson Clues From The Blood Smear 55 OFF
https://imagebank.hematology.org/getimagebyid/64402?size=3
Anemia Lesson Clues From The Blood Smear 55 OFF
https://i.ytimg.com/vi/Y2Op6kWIyJQ/maxresdefault.jpg
Anemia Microcytic MCV Blood smear is examined carefully using 40 x to 100 x objective usually oil immersion lens 2 100 white blood cells are counted 3 Cells are classified by morphology Neutrophils
Direct Coombs test detection of immunoglobulin and or complement molecules on the surface of red blood cells Indirect Coombs test incubates normal red blood cells with patient serum searching for unbound red cell antibody in the patient serum Questions Results Preliminary analysis revealed distinct histogram patterns correlating with specific smear observations varying across different types of anemia These patterns showed statistically significant associations with particular smear findings suggesting potential diagnostic value
More picture related to Blood Smear Interpretation Anemia Chart
Anemia Analysis Chart
https://i.ytimg.com/vi/_542TQN_kvA/maxresdefault.jpg
Anemia Iron Levels Chart
https://img.grepmed.com/uploads/11272/iron-hematology-differential-panel-interpretation-original.jpeg
Anemia Iron Panel Chart
https://i.ytimg.com/vi/Nh8lvOW3ooA/maxresdefault.jpg
Caveat Anemia is a syndrome not a disease An abnormal Hgb or Hct should ALWAYS be investigated if confirmed on repeat testing Immature RBCs released in response to decreased Hgb concentration Increased numbers suggest ongoing RBC loss or destruction reticulocytes show marrow compensation Definition Reduced amount of circulating red blood cells RBC On lab tests Hemoglobin Hgb or hematocrit Hct 2 standard deviations below the mean Hgb
Different blood tests including a complete blood count CBC iron test or B12 test can help diagnose anemia which can have different causes Anemia occurs when there are not enough healthy chronic disease renal insuficiency blood loss and hemolysis Based upon the clinical picture additional testing including iron studies reticulocyte count and renal function tests may be ordered 2 Microangiopathic hemolytic anemia and sp
Morphological Classification Of Anemia The Blood Project
https://www.thebloodproject.com/wp-content/uploads/2023/03/Anemia-CLASS-1536x864.png
Blood Smear Cheat Sheet
https://img.grepmed.com/uploads/11270/blood-peripheral-analysis-smear-clinical-52-original.jpeg

https://www.uptodate.com › contents › diagnostic-approach-to-anemia-i…
A low hemoglobin concentration and or low hematocrit are the parameters most widely used to diagnose anemia The reference range depends on age and sex of the patient as well as other factors such as altitude prevalence of
https://labpedia.net
Direct blood smear or blood in EDTA can be used What are the indications for RBC Morphology Interpretations To diagnose anemia For typing of the anemia How will you Summarize RBC Morphology and Interpretations

Peripheral Blood Smear Test Cost Procedure And Results Drlogy

Morphological Classification Of Anemia The Blood Project

Parts Of A Blood Smear

Types Of Anemia Lab Values Chart NBKomputer

Peripheral Blood Smear

Iron Deficiency Anemia Labs Chart

Iron Deficiency Anemia Labs Chart

Peripheral Blood Smear Lab Report Dinomarkon1
05 Peripheral Blood Smear Examination

All About Anemia Chart Notes Hematology Etsy
Blood Smear Interpretation Anemia Chart - Results Preliminary analysis revealed distinct histogram patterns correlating with specific smear observations varying across different types of anemia These patterns showed statistically significant associations with particular smear findings suggesting potential diagnostic value